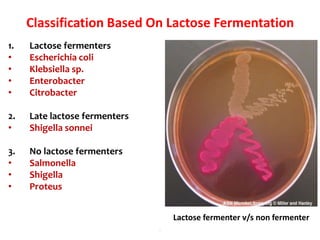
Classification Based On Lactose Fermentation
1. Lactose fermenters
• Escherichia coli
• Klebsiella sp.
• Enterobacter
• Citrobacter
2. Late lactose fermenters
• Shigella sonnei
3. No lactose fermenters
• Salmonella
• Shigella
• Proteus
.
Lactose fermenter v/s non fermenter
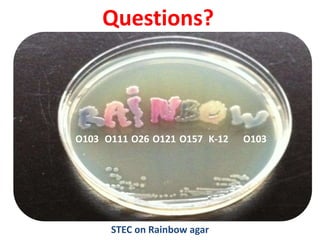
Questions?
STEC on Rainbow agar
O103 O111 O26 O121 O157 K-12 O103

This document provides information on the genus Escherichia coli. It discusses the morphology, culture characteristics, biochemical reactions, antigenic structure, and virulence factors of E. coli. Key points include:
- E. coli is a gram-negative, facultative anaerobic rod that is a normal inhabitant of the gastrointestinal tract.
- It ferments glucose with acid and gas production and is capable of reducing nitrates to nitrites.
- E. coli has O, H, and K surface antigens that are used for serotyping. The O antigen lipopolysaccharide contributes to virulence.
- Virulence factors include surface antigens, fimbriae, and toxins

![LT = HEAT LABILE TOXIN
MOA:
• The B (binding) subunit binds the toxin
to the target cells via a specific receptor
that has been identified as GM1
GANGLIOSIDE.
• The A (Active) subunit is then activated
by cleavage of a peptide bond and
internalized
• The activated subunit A then catalyzes
the ADP-ribosylation (transfer of ADP-
ribose from nicotinamide adenine
dinucleotide [NAD]) of a regulatory
subunit of membrane-bound adenylate
cyclase, the enzyme that converts ATP to
cAMP.
• This activates the adenylate cyclase,
which produces excess intracellular
cAMP, which leads to hypersecretion of
water and electrolytes into the bowel
lumen.
• Diagnosis done by demonstration of the
toxin. .](https://image.slidesharecdn.com/lecture4escherichiacoli-190604030535/85/Genus-Escherichia-coli-28-320.jpg)










![Enterohemorrhagic E. coli (EHEC)
Represented by a single strain
(serotype O157:H7)
Adhesins not characterized,
probably fimbriae
Moderately invasive
Produces shiga toxin but not
LT or ST
Copious bloody discharge
(hemorrhagic colitis), intense
inflammatory response, may
be complicated by hemolytic
uremia
Pediatric diarrhea caused by
this strain can be fatal due to
acute kidney failure
(hemolytic uremic syndrome
[HUS]).
The Lancet 1998 352:1207-1212](https://image.slidesharecdn.com/lecture4escherichiacoli-190604030535/85/Genus-Escherichia-coli-39-320.jpg)